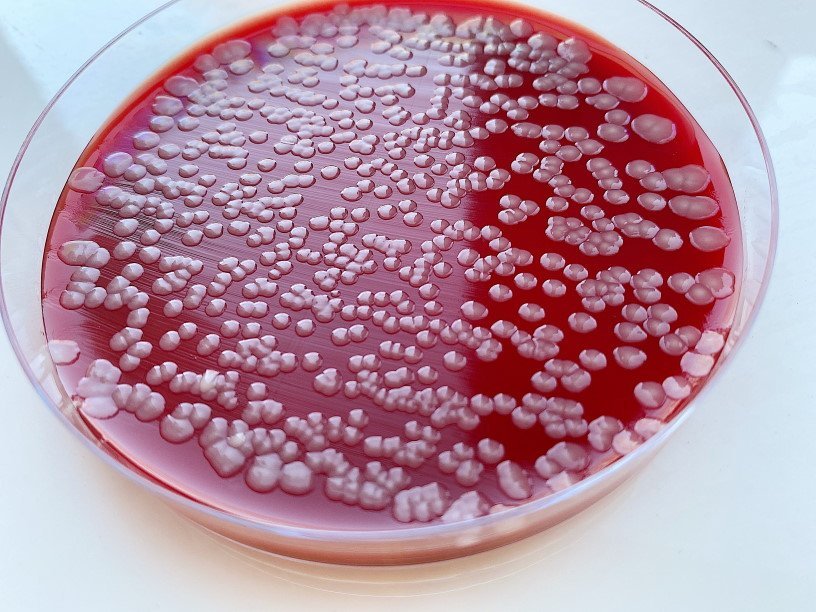

Екатерина Беленко: Промикробы: Клан Сопрано
На прошлой неделе мы начали знакомиться с разными родами из порядка Enterobacterales. Мы поговорили про Shigella, Yersinia и Erwinia. Но на этом увлекательный мир энтеробактерий не заканчивается. Поэтому предлагаю без лишних слов перейти к следующим представителям моего любимого семейства.
⠀
Род Citrobacter — это род грамотрицательных споронеобразующих, факультативно анаэробных бактерий. Они являются представителями нормальной, условно-патогенной микрофлоры кишечника человека. Название род получил не в честь ученого, как мы уже привыкли, а благодаря тому, что они могут использовать цитрат в качестве единственного источника углерода. Цитробактер является одной из самых частых причин внутрибольничных ангиогенных инфекций и инфекций мочевыводящих путей. Цитробактер способен вызывать вспышки гастроэнтеритов и токсикоинфекций, внутрибольничные инфекции, менингиты, абсцессы мозга, урологические заболевания, гнойные инфекции и сепсис у детей и взрослых.
⠀
Источником инфекции являются люди и животные. Механизм передачи цитробактера — фекально-оральный. Основной путь передачи — пищевой, через молоко, молочные продукты, масло, кондитерские изделия, мясо птиц и животных. Болезнь может протекать по типу пищевого отравления в виде гастрита, энтерита или гастроэнтерита. Инкубационный период цитробактериоза — от 2 до 5 часов. Но не человеком единым... Цитробактер способен самостоятельно или в ассоциации с другими микробами также вызывать заболевания у домашних и диких животных, рыб и даже пчёл.
⠀
Род Enterobacter — факультативные анаэробные грамотрицательные бактерии, которые входят в состав нормальной микрофлоры кишечника. Энтеробактер относится к условно-патогенным бактериям, которые при попадании в другие органы вызывают инфекционные заболевания почек, мочевыводящих путей, половых органов, респираторной системы. Enterobacter является одной из самых частых причин внутрибольничных инфекций, обусловленных катетеризацией центральных вен, и инфекций дыхательных и мочевыводящих путей. Эти микробики встречаются повсеместно и могут обсеменять предметы больничной обстановки. Энтеробактер также обитает в кишечнике некоторых видов животных, встречается в почве, воде и пищевых продуктах.
Одним из самых известных представителей этого рода является Enterobacter cloacae. Эти малыши располагаются одиночно, попарно или короткими цепочками. Они подвижны за счёт перитрихов. Широко распространены в природе, встречаются в пресной воде, почве, сточных водах, на растениях, овощах, в испражнениях человека и животных. У человека вызывают кишечные, респираторные, урогенитальные гнойно-воспалительные заболевания, менингит, септицемию, раневые и ожоговые инфекции, бактериемию, диарею и другие различные оппортунистические инфекции.
Род Pantoea — это род грамотрицательных бактерий, недавно отделенный от рода Enterobacter. Систематика бактерий — очень сложная штука, которая продолжает развиваться прямо сейчас, поэтому нет ничего удивительного, что роды и семейства отделяются, объединяются или ещё что-нибудь делают. Так вот, род Pantoea включает в себя не менее 20 видов. Бактерии Pantoea имеют желтую пигментацию, ферментируют лактозу, подвижны и образуют слизистые колонии.
Если вы думаете, что мы обсудили всех энтеробактерий, то вы заблуждаетесь. Кишечный мир огромен и полон тайн!